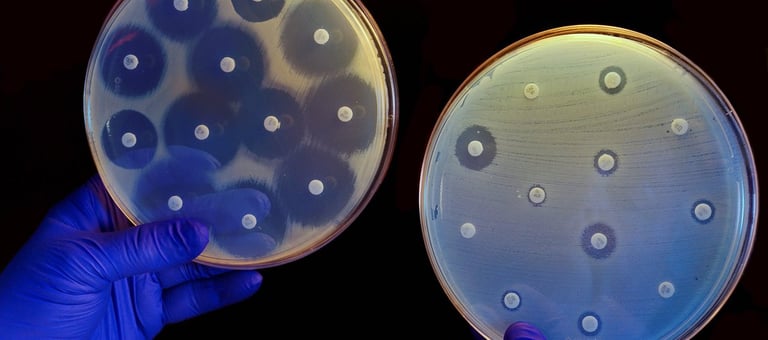
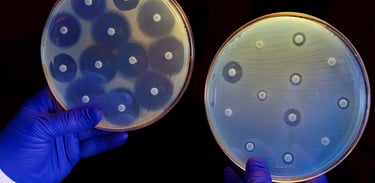

La fagoterapia contra las superbacterias y las enfermedades infecciosas graves
Los bacteriófagos o fagos son, probablemente, el ser más mortífero de nuestro planeta. Pero, ¿qué son exactamente? ¿Por qué son tan peligrosos? Y lo más importante, ¿puede ayudarnos la fagoterapia a combatir enfermedades infecciosas graves?
MICROBIOLOGIAMEDICINAHISTORIA
Los fagos son virus que infectan bacterias. A diferencia de los virus que nos afectan a los humanos, que necesitan entrar en nuestras células para reproducirse, los fagos no pueden infectarnos.
En cambio, pinchan a las bacterias con jeringuillas para inyectar su material genético. En poco tiempo, la bacteria queda conquistada y se ve obligada a crear nuevos fagos.
Este proceso solo se detiene cuando la bacteria está completamente llena de fagos, que liberan una enzima llamada endolisina en el ciclo para destruir la pared celular y liberar todos los nuevos fagos.
¿Qué es la fagoterapia?
Ciclos de los virus bacteriófagos. Cuando los bacteriófagos infectan bacterias, puede ocurrir uno de los dos mecanismos). a) El DNA viral puede entrar a la célula y comenzar una infección (ciclo lítico) o b)el DNA viral, una vez dentro de la célula, puede incorporarse al cromosoma bacteriano, replicarse con el y transferirse a las células hijas (ciclo lisogénico). Las bacterias que albergan a estos virus se conocen como lisogénicas porque, en forma ocasional, estos virus llamados profagos se activan y establecen un nuevo ciclo lítico. Imagen y explicación extraidos de Blog de Biologia
En cierto modo, los fagos son como los depredadores de las bacterias, y han evolucionado junto a ellas durante millones de años. De hecho, son uno de los mayores responsables de muertes en la tierra, pero estamos de suerte porque solo comen bacterias. Por lo tanto, pueden ser una herramienta útil para combatir infecciones bacterianas en humanos.
¿Es seguro utilizar un virus contra las infecciones bacterianas?


La fagoterapia consiste en la utilización de bacteriófagos o virus específicos para cada tipo de infección bacteriana. La fagoterapia data de tiempos previos al descubrimiento de los antibióticos, ya que su primer uso registrado fue en 1919 por el microbiólogo franco-canadiense Felix d'Herelle. Sin embargo, el descubrimiento y pronta producción de los antibióticos durante la segunda guerra mundial, hicieron que la fagoterapia quedara olvidada.
Foto de Diana Polekhina en Unsplash
Bacteriófagos atacando una bacteria. Imagen extraída de la BBC
Con la creciente resistencia de las super bacterias a los antibióticos esta antigua practica a tomado fuerza y podría ser nuestra única esperanza en el futuro.
¿Qué ventajas tiene la fagoterapia vs la antibioticoterapia?
A diferencia de los antibióticos, que matan tanto a las bacterias buenas como a las malas y pueden tener efectos secundarios desagradables, los fagos son muy específicos. Atacan exclusivamente a bacterias específicas o a sus parientes cercanos, lo que significa que pueden ser utilizados para combatir infecciones sin dañar a las bacterias buenas que necesitamos en nuestro cuerpo.
Ataque a bacterias especificas
Bacteriófagos atacando bacterias específicas. Imagen extraída de la BBC
Baja resistencia adquirida
Al contrario de los antibióticos, las bacterias no pueden volverse completamente resistentes a ellos. Esto se debe a que la guerra entre los fagos y las bacterias ha estado peleando por millones de años y los fagos también han evolucionado para ganarles a las bacterias.
El cultivo de la izquierda no es resistente a los antibióticos de los discos, por lo que no puede crecer cerca de ellos. En el de la derecha se produce el caso contrario. Foto de Corton Press para NatGeo
Pero, ¿Y si las bacterias ganan la guerra contra los fagos?
Sin embargo, incluso en el peor de los casos que las bacterias se volvieran resistentes a los fagos, aun podríamos ganar, porque las bacterias al volverse resistentes a los fagos, dejan de ser resistentes a los antibióticos.


¿Por qué no es común la fagoterapia contra las enfermedades infecciosas?
A pesar de los beneficios potenciales de los fagos, aún hay obstáculos que superar. Por un lado, el tratamiento con fagos aún es experimental y no ha sido aprobado oficialmente.
Además, las empresas farmacéuticas son reacias a invertir los miles de millones necesarios en algo que carece de una aprobación oficial.
Foto de Roger Brown para Pexels
El futuro es prometedor para la fagoterapia contra las enfermedades infecciosas
Las cosas están cambiando. En 2016 se inicio el mayor ensayo clínico realizado hasta la fecha y los fagos están recibiendo cada vez más atención.
Y nos conviene acostumbrarnos a ellos, porque la era de los antibióticos como superarmas está llegando a su fin.
Foto de National Cancer Institute en Unsplash